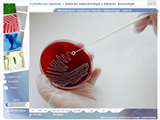

MultiTouch application
Museum multitouch application. All graphic screen elements respond to full touch, slide, rotate, and squeeze. You enlarge photos to see the smallest details while exploring via touchscreen on a 55 inch or larger high def monitor.





Diagnostic methods in clinical microbiology and clinical immunology
Educational software for secondary medical schools and medical colleges. The explanatory part is supported with photographs and videos, newly-gained knowledge testing.

Encyclopedia of cardiosurgery
Vast encyclopedia of cardiosurgery. Double CD by authors that work at the Cardiosurgery Clinic of the University Hospital in Hradec Kralove. It includes 1200 static images and 250 video recordings.





Small Bowel Examination & Atlas of Enteroscopy
A CD (Czech and English versions) that is inserted in the book of the same name.




Protected areas of the Czech Republic
The project acquaints the users with the concept and content of “Nature and Landscape Protection” in the Czech Republic. It gives graphic information on general and special environmental protection of species and land/water areas, non-living nature protection, and park and farm greenery protection.




GRADA MS Access 2002
Visual guide that teaches the beginner user, "step by step", to work with a relational database system. Explanations, animated illustrations, screen shots, tests, practical animated guide.



GRADA MS Word 2002
This software can quickly, and in a self-explanatory way, teach any beginner to utilize text editor features very efficiently. Explanations, animated illustrations, screen shots, tests, practical animated guide.



GRADA MS Excel 2002
A visual guide teaches the beginner user, "step by step", to work with a table calculator. Explanations, animated illustrations, screen shots, tests, practical animated guide.


